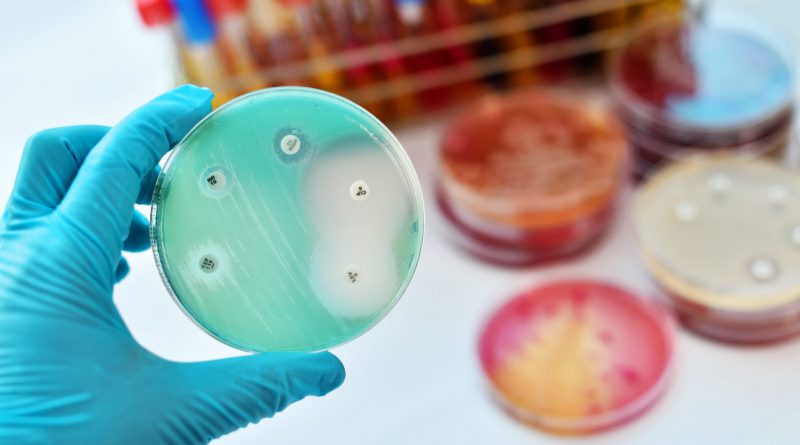

Buscan darle propiedades antibacterianas a los respiradores artificiales
Investigadores del Conicet y de la Universidad Nacional de La Plata trabajan en un proyecto para aplicar antimicrobianos sobre el tubo endotraqueal y evitar las neumonías asociadas a su uso en los pacientes con coronavirus, informó el Conicet.
Se trata de un proyecto de investigación de los integrantes del Grupo Nanosuperficies Biofuncionales (NanoSBio) del Instituto de Investigaciones Fisicoquímicas Teóricas y Aplicadas (Inifta, Conicet-UNLP), que fue seleccionado junto a otras 136 iniciativas en todo el país en una convocatoria del Ministerio de Ciencia, Tecnología e Innovación de la Nación (MINCyT).
“Nosotros diseñamos superficies autoesterilizables, y trabajamos particularmente con implantes que tienen riesgo de ser colonizados por bacterias, como por ejemplo los tornillos que se utilizan en cirugías de columna o los clavos endomedulares para tratar fracturas”, relató Diego Pissinis, investigador del Conicet en el Inifta.
El investigador es responsable del proyecto titulado “Tratamiento de la neumonía asociada a la ventilación mecánica: cofactor de mortalidad en pacientes Covid-19 positivos”, por el que el grupo recibirá un financiamiento especial.
“Lo que suele suceder es que, al momento de introducir el material en el cuerpo, inmediatamente es colonizado por microorganismos que pueden estar previamente en el paciente o provenir del ambiente, por más aséptico que sea el quirófano o el procedimiento llevado a cabo por el personal de salud”, detalló.
Explicó que “esos microbios generan una película llamada biofilm, capaces de generar infecciones muy severas”.
Lo que proponen los científicos es incorporar agentes antimicrobianos al dispositivo que ingresa al organismo.
La modificación de la superficie que los científicos proponen consiste es la aplicación de un hidrogel sobre el tubo.
“Se trata de un polímero, es decir un material compuesto por grandes moléculas, que forma una red tridimensional capaz de absorber grandes cantidades de agua. Se lo puede cargar con agentes antimicrobianos, que se irán liberando progresivamente. Si además el hidrogel es biodegradable, esa separación se produce de dos maneras: por la difusión dentro de su malla y por su propia degradación”, precisó el experto.